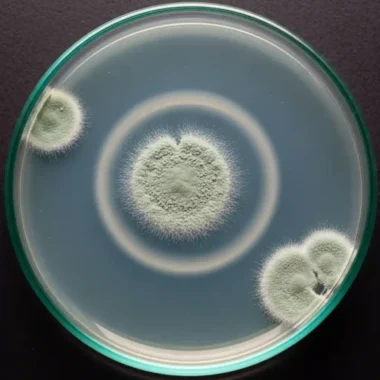
페니실린 탄생 비화

1928년, 페니실린 탄생 비화, 알렉산더 플레밍의 실험실: 인류를 구한 우연한 발견
만약 당신이 1920년대에 살고 있다면, 단순한 상처나 감염이 곧 사형 선고와 같았다. 폐렴, 패혈증, 심지어 작은 종기 하나도 치명적이었다. 인류는 수천 년간 세균과의 보이지 않는 전쟁에서 속수무책이었다. 이러한 절망적인 시대에, 한 과학자의 부주의함과 날카로운 관찰력이 인류의 운명을 영원히 바꾸는 기적을 낳았다. 그 기적의 이름은 페니실린이며, 그 시작은 1928년 런던 세인트 메리 병원의 한 지저분한 실험실이었다.
페니실린의 탄생은 단순한 의약품 개발이 아니라, 인류가 질병에 맞서는 방식을 근본적으로 재정의한 과학 혁명이었다. 이 기사는 알렉산더 플레밍의 우연한 발견부터 현대 의학의 초석이 되기까지 페니실린이 걸어온 서사적 여정을 추적한다.

우연이 빚어낸 운명적 순간: ‘곰팡이 포자’의 침입
1928년 9월, 스코틀랜드 출신의 세균학자 알렉산더 플레밍(Alexander Fleming)은 여름휴가를 마치고 자신의 실험실로 돌아왔다. 그의 실험실은 정리정돈과는 거리가 멀었고, 배양 접시들이 여기저기 쌓여 있었다. 그는 포도상구균(Staphylococcus)을 연구하고 있었는데, 그중 뚜껑이 열린 채 방치됐던 배양 접시 하나에서 이상한 현상을 발견했다. 접시 위에는 푸른곰팡이(Penicillium notatum)가 피어 있었는데, 놀랍게도 곰팡이 주변으로는 포도상구균이 전혀 자라지 않고 용해된 듯한 흔적만 남아 있었다.
대부분의 과학자라면 오염된 배양 접시를 버렸겠지만, 플레밍은 이 현상을 대수롭지 않게 넘기지 않았다. 그는 이 곰팡이가 세균의 성장을 억제하는 어떤 물질을 분비하고 있다고 직감했다. 플레밍은 이 물질을 곰팡이의 이름(Penicillium)을 따서 ‘페니실린(Penicillin)’이라고 명명했다. 이는 인류 역사상 최초의 항생제 발견으로 기록됐으며, 지저분한 실험실에 우연히 침입한 곰팡이 포자가 인류를 구하는 운명적인 순간이 됐다.
돌봄의 굴레를 끊다: 발달장애인 주간활동서비스, 성인 발달장애인의 의미 있는 낮 시간을 설계하다
플레밍의 통찰, 그리고 잊힌 10년의 공백
플레밍은 페니실린이 강력한 항균력을 가지고 있으며, 인체에 무해하다는 사실을 밝혀냈다. 그는 페니실린이 감염 치료에 혁명적인 잠재력을 갖고 있다고 확신했지만, 한계에 부딪혔다. 당시의 기술로는 페니실린을 순수한 형태로 분리하고 대량 생산하는 것이 극도로 어려웠다. 페니실린은 불안정했고, 추출 과정에서 쉽게 파괴됐다. 플레밍은 페니실린을 국소 소독제로 사용하거나 연구 목적으로만 활용하는 수준에 머물렀고, 1930년대 내내 이 놀라운 발견은 학계의 큰 주목을 받지 못한 채 잊히는 듯했다.
이러한 공백은 약 10년간 지속됐는데, 이 기간 동안 수많은 사람들이 치료 가능한 감염으로 목숨을 잃었다. 플레밍은 자신의 발견을 포기하지 않았지만, 복잡한 화학적 난제를 해결할 수 있는 전문적인 팀과 자원이 부족했다. 이는 위대한 발견이 실용화되기 위해서는 단순한 통찰력 외에도 후속 연구와 기술 발전이 필수적임을 보여주는 역사적 사례가 됐다.
전쟁의 그림자 속에서 꽃핀 실용화: 플로리와 체인의 역할
페니실린이 다시 빛을 보게 된 것은 제2차 세계대전의 그림자가 짙게 드리운 1940년대 초였다. 옥스퍼드 대학교의 병리학자 하워드 플로리(Howard Florey)와 생화학자 에른스트 체인(Ernst Chain)은 플레밍의 초기 연구에 주목했다. 전쟁이 발발하면서 부상병들의 감염 치료가 시급해졌고, 이들은 페니실린의 잠재력을 실현하기 위해 대규모 연구에 착수했다.
플로리와 체인 팀은 화학적 난제를 해결하고 페니실린을 안정적으로 정제하는 방법을 개발하는 데 성공했다. 1941년, 이들은 최초로 인간에게 페니실린을 투여하는 임상 시험을 진행했고, 그 결과는 놀라웠다. 비록 초기에는 생산량이 극히 적었지만, 페니실린은 감염된 환자들을 기적적으로 회복시켰다.
미국과 영국의 정부 및 제약 회사들은 전쟁 수행에 필수적인 이 물질의 대량 생산에 막대한 투자를 했고, 1944년 노르망디 상륙작전 무렵에는 페니실린이 연합군 부상병 치료에 광범위하게 사용됐다. 페니실린은 전쟁의 승패를 가르는 ‘비밀 무기’ 중 하나로 불릴 정도로 그 영향력이 막대했다.
페니실린이 바꾼 인류의 역사와 현대적 과제
페니실린의 등장은 평균 수명을 획기적으로 늘리고, 수많은 질병을 정복하는 현대 의학의 토대가 됐다. 플레밍, 플로리, 체인은 이 공로를 인정받아 1945년 노벨 생리의학상을 공동 수상했다. 이로써 인류는 세균 감염을 더 이상 두려워하지 않는 ‘항생제 시대’를 맞이하게 됐다. 페니실린은 단순한 약을 넘어, 인류가 질병과의 싸움에서 우위를 점하게 만든 문명사적 전환점이었다.
그러나 페니실린의 성공은 또 다른 심각한 과제를 낳았다. 항생제의 오남용으로 인해 세균들이 약물에 저항하는 ‘항생제 내성(Antibiotic Resistance)’을 갖게 됐기 때문이다. 플레밍은 노벨상 수상 연설에서 이미 이 위험성을 경고한 바 있다. 그는 페니실린을 너무 적은 용량으로 투여하거나 오용할 경우, 박테리아가 약물에 저항하는 내성을 갖게 될 것이라고 지적했다. 불행하게도 그의 예언대로 항생제는 남용됐고, 이로 인해 메티실린 내성 포도상구균(MRSA)과 같은 ‘슈퍼박테리아(Superbug)’가 출현했다. 현대 의학은 다시 세균과의 싸움에서 중대한 위기에 직면했다. 페니실린 발견 100주년을 앞둔 지금, 인류는 세균의 진화 속도를 따라잡을 새로운 항생제 개발과 항생제 오용에 대한 경각심을 높이는 숙제를 안게 됐다.
알렉산더 플레밍의 우연한 발견은 인류에게 구원의 빛을 선사했으나, 동시에 과학적 성과가 가져온 문명사적 책임감까지 남겼다. 1928년 런던의 한 실험실에서 시작된 작은 곰팡이 포자는 인류가 질병과의 싸움에서 우위를 점하는 ‘항생제 시대’를 열었다. 그러나 이 시대를 지속하기 위한 지혜는 끊임없이 모색해야 하는 인류의 영원한 과제가 됐다. 페니실린의 서사적 여정은 위대한 발견이 인류를 구원할 수 있지만, 그 성과를 현명하게 보존하는 것은 오롯이 후대의 책임임을 보여준다.

당신이 좋아할만한 기사
기린의 초고혈압 비밀, 기린 심장의 압력, 인간의 2배
